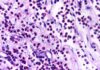
Эозинофилы: о чем говорит повышение уровня клеток-«чистильщиков» в крови

Содержание статьи:
Вермейл в золотом: Анализ сюжета и персонажей
Аниме-сериал «Вермейл в золотом» («Vermeil in Gold») представляет собой увлекательное сочетание романтической комедии, фэнтези и элементов магического реализма. Сюжет закручивается вокруг Альто Голдфиллда, студента первого курса магической академии «Ортигия», столкнувшегося с серьезной проблемой: неудача в призыве фамильяра грозит ему остаться на второй год. Давление со стороны сверстников и желание избежать позора толкают его на отчаянные меры. Эта ситуация, полная комедийных недоразумений и напряженных моментов, составляет основу динамичного повествования сериала.

Встреча Альто и Вермейл: Комедия и неожиданные отношения
Центральный конфликт сериала завязан на специфическом ритуале призыва фамильяров. Альто, не имея достаточных знаний и навыков, пытается найти информацию в библиотеке академии. Именно там он обнаруживает древнюю книгу, содержащую описание ритуала, который, как он наивно полагает, поможет ему избежать академической неудачи. Однако, вместо ожидаемого послушного и полезного фамильяра, Альто призывает Вермейл – могущественную демоницу, известную своей разрушительной силой и склонностью к катастрофам. Этот неожиданный поворот событий кардинально меняет жизнь молодого мага и вносит хаос в размеренную жизнь академии.
Встреча Альто и Вермейл полна комических ситуаций. Появление демоницы в полностью обнаженном виде – яркий пример неожиданности и неловкости, которая остро подчеркивает контраст между ожиданиями Альто и реальностью. Однако, несмотря на шок и смущение, Альто сохраняет хладнокровие и, не теряя присутствия духа, произносит слова призыва, заключая Вермейл в качестве своего фамильяра. Этот акт смелости и решительности, несмотря на нестандартные обстоятельства, определяет дальнейшее развитие их отношений.
Любовный треугольник и другие персонажи
Отношения между Альто и Вермейл – это сердцевина сюжета. Они построены на необычном симбиозе: Вермейл нуждается в постоянной подпитке магической энергией, которую получает от Альто посредством поцелуя. Этот интимный акт, несмотря на свою необычность, является неотъемлемой частью их связи и служит источником как комических, так и романтических моментов в сериале. Эта зависимость создает непредсказуемую динамику в их отношениях, постоянно балансируя между неловкостью, взаимной заботой и романтическим напряжением.
Помимо Альто и Вермейл, значимую роль в сериале играет Лилия Кудельфейт – давняя подруга Альто, которая испытывает к нему романтические чувства. Появление Вермейл становится для Лилии серьезным испытанием, вызывая у нее ревность и заставляя переосмыслить свои отношения с Альто. Ее реакция на необычную пару – смесь недоумения, раздражения и скрытой зависти – добавляет в сериал слой интриги и усиливает эмоциональную составляющую повествования.
Характеры главных героев прописаны достаточно ярко. Альто – типичный представитель «среднестатистического» студента, не обладающего выдающимися магическими способностями, но отличающийся упорством и способностью принимать нестандартные решения. Вермейл – яркая и харизматичная демоница, сложная и противоречивая личность. Ее внешняя дерзость и склонность к разрушительным действиям скрывают глубину и неожиданную нежность. Лилия – милая и заботливая девушка, но в то же время решительная и способная на смелые поступки, что делает ее интересным и многогранным персонажем.
Гармония жанров и визуальное исполнение
Сериал «Вермейл в золотом» удачно сочетает в себе динамичный сюжет, интересных персонажей и атмосферную рисовку. Юмор, романтические отношения и магическая составляющая гармонично переплетаются, создавая запоминающееся и увлекательное кинопроизведение. Авторы успешно балансируют между комедийными ситуациями и более серьезными моментами, подчеркивая сложность взаимоотношений между главными героями.
Адаптация манги «Вермейл в золотом: Сильнейший маг проходит через магический мир с сильнейшей катастрофой» в аниме-сериал сохранила основные сюжетные линии и характеры персонажей. Аниме добавляет динамики и визуальной привлекательности, расширяя мир истории и подчеркивая эмоциональные моменты. Сериал привлекает зрителя своим оригинальным сюжетом, яркими персонажами и уникальным сочетанием жанров.
Заключение
В заключение, «Вермейл в золотом» – это забавное и увлекательное аниме, которое умело сочетает комедийные и романтические элементы с фэнтезийным миром и интересным развитием сюжета. Главные герои яркие и запоминающиеся, их взаимоотношения полны непредсказуемости и динамики. Сериал оставляет приятное впечатление и заставляет с нетерпением ждать продолжения. Смотреть аниме «Вермейл в золотом» можно на специализированных сайтах.